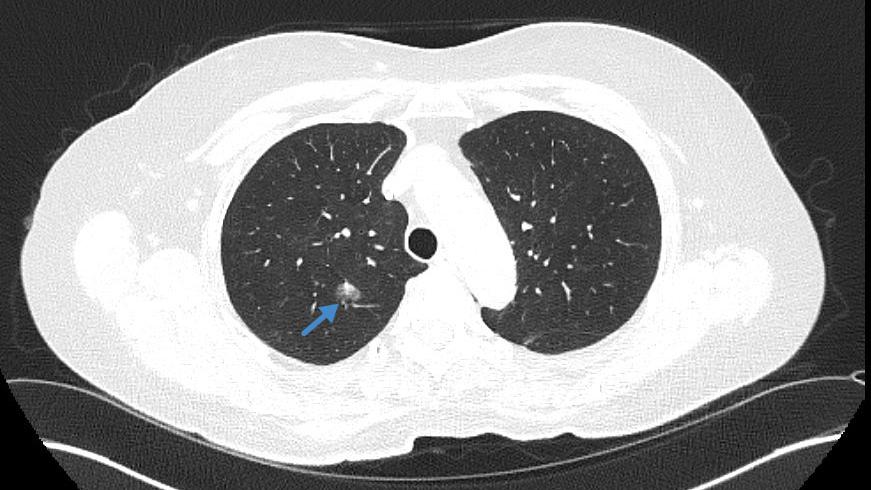
Beste Chancen dank früher Diagnose: CT-Aufnahme der Lunge einer älteren Patientin und ehemaligen Raucherin mit auffälligem Herd (siehe blauer Pfeil). Die weitere Abklärung ergab, dass es sich dabei um einen bösartigen Tumor handelt. Die Patientin konnte erfolgreich operiert werden und hat daher beste Aussichten dauerhaft geheilt zu sein. © TUM Klinikum

TUM Klinikum Rechts der Isar bietet Lungenkrebs-Früherkennung für starke Raucherinnen und Raucher an


„Lungenkrebs im frühen Stadium ist heilbar“, erklärt Prof. Dr. med. Hans Hoffmann, Leiter der Sektion für Thoraxchirurgie am TUM Klinikum Rechts der Isar. „Das Problem ist: Man spürt frühen Lungenkrebs nicht, er bereitet keine Schmerzen – und man kann ihn von außen auch nicht ertasten.“ Per CT-Untersuchung lasse er sich in diesem Stadium aber bereits entdecken.
Am TUM Klinikum kommen hierfür ab sofort besonders schonende Niedrigdosis-CT-Geräte zum Einsatz. „Sie bieten exzellente Bildqualität bei sehr geringer Strahlenbelastung“, sagt Privatdozentin Dr. med. Lisa Adams, Leitende Oberärztin am Institut für diagnostische und interventionelle Radiologie. „Damit lassen sich selbst kleine Lungenrundherde im Millimeterbereich sicher erkennen.“
Denn selbst mit Niedrigdosis-Geräten bedeutet eine Computertomografie immer noch eine gewisse Strahlenbelastung. „Sie ist daher nur für Menschen empfehlenswert, die ein überdurchschnittlich hohes Risiko für Lungenkrebs haben“, sagt Prof. Hoffmann. Das Lungenkrebs-Screening – durch Beschluss des Gemeinsamen Bundesausschuss (G-BA) kürzlich neu ins Angebot zur Krebsfrüherkennung aufgenommen – richtet sich daher ausschließlich an starke Raucherinnen und Raucher im Alter zwischen 50 und 75 Jahren, die mindestens 25 Jahre geraucht haben. Als „stark“ gilt dabei ein Konsum von 15 „Packungsjahren“. Dabei bedeutet ein Packungsjahr, dass eine Person ein Jahr lang täglich eine Packung zu je 20 Zigaretten geraucht hat. Auch wer den Rauchstopp geschafft hat, darf bis zu zehn Jahre danach noch am Screening teilnehmen.
„Rauchen ist ein anerkannter und unstrittiger Risikofaktor für die Entwicklung von Lungenkrebs“, sagt Privatdozent Dr. med. Gregor S. Zimmermann, Leiter der Sektion Pneumologie am TUM Klinikum. „Da Rauchen der Hauptrisikofaktor für Lungenkrebs ist, konzentriert sich auch die Früherkennung auf Raucherinnen und Raucher bzw. ehemalige Raucherinnen und Raucher.“ Studien (siehe Infobox unten) belegen bislang nur für diese Gruppen, dass sich die Sterblichkeit durch Lungenkrebs durch ein Screening signifikant senken lässt. Zwar können auch Nichtraucherinnen und Nichtraucher an Lungenkrebs erkranken. Für sie ist der Nutzen der Früherkennung aber nicht belegt.
Derzeit müssen auch Menschen mit sehr hohem Risiko die Kosten für das Lungenkrebs-Screening noch selbst tragen. Durch den G-BA-Beschluss wird sich das jedoch bald ändern: Voraussichtlich ab April 2026 wird das Angebot eine Kassenleistung. Aber schon jetzt ist das Screening ein Novum: „Das Lungenkrebsscreening ist das erste Früherkennungsprogramm in Deutschland, bei dem Künstliche Intelligenz (KI) verpflichtend eingesetzt wird“, sagt Dr. Adams. „Sie stellt eine einheitliche Auswertung sicher und unterstützt Radiologinnen und Radiologen dabei, kleinste Veränderungen früh und reproduzierbar zu erkennen.“ Prof. Dr. med. Marcus R. Makowski, Direktor des Instituts für diagnostische und interventionelle Radiologie am TUM Klinikum, sagt: „Mit dem CT-Niedrigdosis-Lungenkrebsscreening und der KI-basierten Analyse lässt sich Lungenkrebs früh erkennen und die Heilungschance verbessern.“
Wurde ein Tumor in der Lunge entdeckt, bedeutet das allerdings nicht zwingend, dass es sich tatsächlich um Krebs handelt. „Durch eine CT-Untersuchung werden auch viele gutartige Herde entdeckt“, erklärt Prof. Hoffmann. Es sei nicht leicht, diese von bösartigen Tumoren zu unterscheiden. In Lungenkrebszentren wie dem kürzlich neu zertifizierten gemeinsamen Zentrum des TUM Klinikums mit dem Krankenhaus Martha-Maria München werden daher alle Befunde in einer Tumorkonferenz von erfahrenen Ärztinnen und Ärzten für Pneumologie, Radiologie und Thoraxchirurgie gemeinsam bewertet.
War die CT-Untersuchung ohne Befund, sollte sie nach einem Jahr wiederholt werden. Zum Angebot gehört aber nicht nur die Früherkennung. „Ein wichtiger Bestandteil ist auch die Aufklärung über die Gefahren des Rauchens“, sagt Dr. Zimmermann. „Raucherinnen und Raucher werden daher entsprechend aufgeklärt und motiviert, das Rauchen aufzugeben.“ Je früher sie das schaffen, desto besser: Durch einen Rauchstopp sinke nicht nur das Risiko für Lungenkrebs, sondern auch für andere schwere Lungenerkrankungen wie COPD, aber auch für Herz-Kreislauf-Erkrankungen. „Spezielle Kurse zur Rauchentwöhnung können hierbei unterstützen, ebenso elektronische Hilfsmittel wie Smartphone-Apps.“